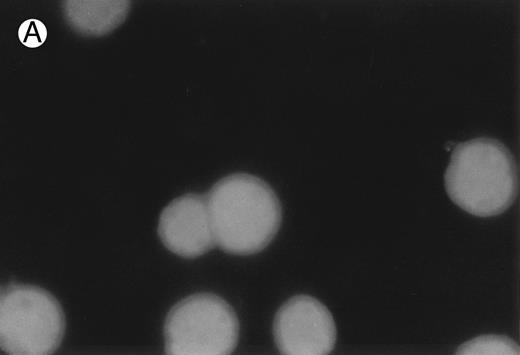
Fig. 2. CD437-induced apoptosis in HL-60R cells. HL-60R cells were grown as described in the Materials and Methods and exposed to either vehicle alone or CD437 (1 μmol/L) for 24 hours and then stained with aciridine orange. (A) Cells exposed to only vehicle. (B) Cells exposed to CD437 (1 μmol/L).

Abstract
Trans retinoic acid (RA) has proven to be a potent therapeutic agent in the treatment of acute promyelocytic leukemia. Unfortunately, other subtypes of acute myelogenous leukemia are resistant to the antiproliferative and differentiating effects of RA. In this report, we describe a novel retinoid 6-[3-(1-adamantyl)-4-hydroxyphenyl]-2-naphthalene carboxylic acid (AHPN; CD437) that not only totally inhibits the proliferation of RA-resistant leukemic cell lines HL-60R and K562 but also induces apoptosis in these cells. Exposure of HL-60R to CD437 results in the rapid (within 30 minutes) increase of the cyclin-dependent kinase inhibitor p21waf1/cip1 as well as GADD45 mRNA. Manifestations of CD437-mediated programmed cell death are noted within 2 hours, as indicated by both the cleavage and activation of the CPP32 protease and cleavage of poly (ADP-ribose) polymerase. This is followed by cleavage of bcl-2 and internucleosomal DNA degradation. HL-60R cells do not express the retinoid nuclear receptor RARβ and RARγ and express a truncated RARα. Thus, CD437 induction of p21waf1/cip1 and GADD45 mRNAs and apoptosis occurs through a unique mechanism not involving the retinoid nuclear receptors. CD437 represents a unique retinoid with therapeutic potential in the treatment of myeloid leukemia.
RETINOIDS HAVE BEEN found to inhibit the growth and induce differentiation of a number of leukemic cells and to inhibit the proliferation of a wide variety of both normal and malignant cell types.1-4 Retinoic acid (RA) has been found to inhibit the growth of primarily estrogen receptor (ER)-positive breast carcinoma cell lines.5-8 Retinoids mediate their antiproliferative action as well as their ability to induce differentiation through their binding and activation of specific nuclear receptors, ie, RARs or RXRs (Giguere,9 Gudas,10 and Mangelsdorf and Evans11 and the references within those reports). These activated nuclear receptors, in turn, bind to specific DNA sequences referred to as consensus sequences that are located in the regulatory portions of genes and thus, in turn, modulate gene activity.9-11 These liganded nuclear receptors can also inhibit gene expression through their ability to complex with transcription factors and thus inhibit AP-1–mediated gene transcription.12 13
We have previously described a novel retinoid 6-[3-(1-adamantyl)-4-hydroxyphenyl]-2-naphthalene carboxylic acid (AHPN; CD437) that induces G1 arrest and apoptosis in human breast carcinoma cells.14 CD437, although displaying extremely poor binding and transactivation of RARα and RARβ, binds and transactivates RARγ in CV-1 cells at a concentration resulting in half-maximal activation ED50 that is approximately three times higher than that found with RA.15 In addition, CD437 does not bind to or transactivate the RXRs. ER-positive breast carcinoma cells express RARα and RARγ, whereas ER-negative cells in general express only RARγ and are refractory to the antiproliferative effects of RA.6-8 We have found that CD437 is a much poorer transactivator of the endogenous RARs and RXRs than RA in ER-negative breast carcinoma cells that are sensitive to CD437-mediated G1 arrest and apoptosis but resistant to RA-mediated growth arrest.14 These results suggest that CD437 mediates its action independent of RARγ expression.14 In addition, contrary to RA, CD437 does not display anti–AP-1 activity in breast carcinoma cells.14
To further document that CD437 exerts its effects through an RAR/RXR-independent pathway and independent of RARγ expression, we investigated the ability of CD437 to inhibit the growth and induce apoptosis in HL-60R cells. HL-60R cells do not express RARγ or RARβ, as shown by RNase protection assays, and express a truncated RARα that displays a 10-fold higher kd in terms of RA binding than the normal RARα receptor.16 17 We have found that HL-60R cells are exquisitely sensitive to CD437-mediated growth arrest and apoptosis. In addition, CD437 modulates the expression of the GADD45 and p21waf1/cip1 genes in these cells. These results strongly suggest that CD437 mediates its effects independently of RARγ expression and through a RAR/RXR-independent pathway. More importantly, we also show that CD437 is a potent inducer of apoptosis in both RA-sensitive and -resistant leukemic cell lines as well as fresh leukemic cells obtained from patients.
MATERIALS AND METHODS
Material.RPMI 1640 medium and fetal bovine serum were obtained from GIBCO-BRL (Grand Island, NY). α[32P] dCTP (3,000 Ci/mmol−1) and the ECL Western blotting system were obtained from Amersham (Arlington Heights, IL). The antihuman bcl-2 antibodies were obtained from Genosys Biotechnology (The Woodlands, TX). The antihuman actin antibody was purchased from Sigma (St Louis, MO). The mouse antihuman poly (ADP-ribose) polymerase (PARP) antibody has been previously described.18 All trans retinoic acid (RA) was purchased from Sigma Chemicals. 6-[3-(1-adamantly)-4 hydroxyphenyl]-2-naphthalene carboxylic acid was synthesized as described by Charpentier et al.19
cDNA probes.The full-length human WAF1 cDNA20 probe was kindly provided by Drs K. Kinzler and B. Vogelstein (Johns Hopkins University, Baltimore, MD). A nearly full-length 1.4-kb human GADD45 cDNA probe21 was provided by Dr Michael Kastan (Johns Hopkins University). The 36B4 cDNA probe has been previously described22 and was kindly given by Dr Beth Martin (National Institutes of Health, Bethesda, MD). The plasmid clone HH CSA 65 containing the 1.5-kb cDNA insert specific for the human 18S ribosomal RNA was obtained from American Type Culture Collection (Rockville, MD). The cDNA probes were labeled using the method of Feinberg and Vogelstein.23
Cell lines and growth conditions.HL-60R was kindly supplied by Dr Steve Collins (University of Washington, Seattle, WA). HL-60 and K562 cells were obtained from Dr Douglas Ross (University of Maryland at Baltimore, Baltimore, MD). Cells were grown in RPMI 1640 medium supplemented with 5% heat-inactivated fetal bovine serum and gentamicin (25 μg/mL) in a 5% CO2 /95% air and 100% humidity atmosphere. Leukemic blasts from patients were isolated using Ficoll hypaque. Cells were collected at the interface between plasma and red blood cells and diluted with sterile phosphate-buffered saline (PBS). The cell suspension was then layered over Ficoll hypaque (1.077 density) and the leukemic blasts isolated at the interface. The sample represented greater than 80% blasts.
Northern blots.RNA was isolated using the single-step method of Chomczyski and Sacchi.24 Electrophoresis, transfer, washing conditions, and hybridizations were performed as previously described.25 Equivalent loading was confirmed by hybridization to the housekeeping gene 36B4 or the 18S ribosomal RNA gene.22 The bands were quantified using a Molecular Dynamics Densitometer (Sunnyvale, CA).
Western blots.Western blots were performed essentially as we have described.26 Logarithmically growing cells were treated with CD437 for various times and cells were harvested and lysed in Laemmli lysis buffer (500 mmol/L Tris-HCl, pH 6.8, 2 mmol/L EDTA, 10% glycerol, 10% sodium dodecyl sulfate, and 5% β-mercaptoethanol). Protein lysates (150 μg/lane) were electrophoresed on 12% sodium dodecyl sulfate-polyacrlyalamide gels and transferred to nitrocellulose membranes. The filters were blocked with 5% nonfat dried milk in 1× PBS/0.5% Tween 20 and then incubated with the appropriate antibodies.
Horseradish peroxidase-conjugated rabbit antimouse IgG (Biorad Laboratories, Hercules, CA) was used as the secondary antibody and the bands were developed using the Amersham ECL nonradioactive method per the manufacturer's instructions.
Apoptosis quantification.Apoptotic cell staining was performed as previously described.27 In brief, after exposure to CD437, cells were harvested, washed with PBS, and resuspended at 1 × 106 cells/mL. Fifty microliters of cell suspension was stained with 5 mL of a solution of acridine orange (100 mg/mL in PBS) in the dark. DNA isolation and electrophoresis were performed as we have previously described.14
RESULTS
CD437 inhibition of HL-60R growth and induction of apoptosis.Although HL-60R cells are resistant to RA-mediated inhibition of growth,16,17 they are exquisitely sensitive to CD437-mediated inhibition of growth (Fig 1A) with as little as 25 nmol/L CD437 inhibiting growth by approximately 50% (Fig 1B). Similar inhibition of growth was noted in the parental HL-60 cell line (Fig 1C), as well as the RA-resistant K562 leukemia cell line28 (Fig 1D). As evidenced in Fig 1A, there was not only a total inhibition of cellular proliferation in the presence of CD437 but an actual cell loss. We therefore examined whether CD437 induced programmed cell death (apoptosis) in the HL-60R cells. That CD437 indeed induced apoptosis in the HL-60R cells was documented using three independent parameters. (A) HL-60R cells after exposure to 1 μmol/L CD437 displayed marked nuclear fragmentation and chromatin condensation, with the nuclear and cytoplasmic membranes remaining intact (Fig 2), a morphology indicative of apoptosis.29 (B) Incubation of HL-60R cells with 1 μmol/L CD437 resulted in internucleosomal cleavage and laddering of the DNA on gel electrophoresis (Fig 3), a hallmark of apoptosis.29 (C) A number of studies have suggested a critical role for cysteine proteases in the apoptotic process.30-37 Numerous substrates for this family of proteases have now been identified.37-41 PARP, which plays an important role in both DNA synthesis and repair, is cleaved early in the apoptotic process.37 38
(A) CD437 inhibition of HL-60R proliferation. HL-60R cells were seeded in RPMI 1640 at a cell density of 5 × 104 cells/mL. Cells were incubated overnight, after which vehicle alone (dimethyl sulfoxide at 0.1% final concentration) or CD437 (1 μmol/L final concentration) were added. Cells were harvested at various times and cell number determined using a hemocytometer. (B) HL-60R cells were grown as described above in the presence of various concentrations of CD437 for 48 hours. (C) HL-60 cells grown in the presence and absence of 1 μmol/L CD437, as described above. (D) K562 cells were grown as described above in the absence or presence of CD437 (1 μmol/L).
(A) CD437 inhibition of HL-60R proliferation. HL-60R cells were seeded in RPMI 1640 at a cell density of 5 × 104 cells/mL. Cells were incubated overnight, after which vehicle alone (dimethyl sulfoxide at 0.1% final concentration) or CD437 (1 μmol/L final concentration) were added. Cells were harvested at various times and cell number determined using a hemocytometer. (B) HL-60R cells were grown as described above in the presence of various concentrations of CD437 for 48 hours. (C) HL-60 cells grown in the presence and absence of 1 μmol/L CD437, as described above. (D) K562 cells were grown as described above in the absence or presence of CD437 (1 μmol/L).
CD437-induced apoptosis in HL-60R cells. HL-60R cells were grown as described in the Materials and Methods and exposed to either vehicle alone or CD437 (1 μmol/L) for 24 hours and then stained with aciridine orange. (A) Cells exposed to only vehicle. (B) Cells exposed to CD437 (1 μmol/L).
CD437-induced apoptosis in HL-60R cells. HL-60R cells were grown as described in the Materials and Methods and exposed to either vehicle alone or CD437 (1 μmol/L) for 24 hours and then stained with aciridine orange. (A) Cells exposed to only vehicle. (B) Cells exposed to CD437 (1 μmol/L).
DNA fragmentation induced by CD437 in HL-60R cells. HL-60R cells were grown as described in the Materials and Methods. CD437 was added to a final concentration of 1 μmol/L and cells were harvested. DNA was extracted and fractionated by gel electrophoresis as described in the Materials and Methods.
DNA fragmentation induced by CD437 in HL-60R cells. HL-60R cells were grown as described in the Materials and Methods. CD437 was added to a final concentration of 1 μmol/L and cells were harvested. DNA was extracted and fractionated by gel electrophoresis as described in the Materials and Methods.
As shown in Fig 4, exposure of HL-60R cells to CD437 for 2 hours results in the cleavage of the 116-kD PARP to the 85-kD fragment noted in many forms of programmed cell death.42 Numerous members of the interleukin-1β–converting enzyme (ICE) family of cysteine proteases have been implicated in this cleavage of PARP.37,38,42 Recent evidence suggests that YAMA/CPP32 is responsible for this cleavage.42 We therefore examined YAMA/CPP32 expression in CD437-treated HL-60R cells and found that YAMA/CPP32 is highly expressed in HL-60 cells (Fig 5; data not shown). YAMA/CPP32 is also rapidly cleaved in HL-60 cells after exposure to 1 μmol/L CD437 (Fig 5). This cleavage most likely represents activation of the proform, because, whereas most cells contain an abundance of the precursors of the various cysteine proteases, these precursors must be cleaved at aspartate residues and assembled into enzymatically active heterotetramers.37
CD437-mediated PARP cleavage. HL-60R cells were grown as described in the Materials and Methods and exposed to 1 μmol/L CD437. Cells were harvested at various times and Western blots were performed as described in the Materials and Methods.
CD437-mediated PARP cleavage. HL-60R cells were grown as described in the Materials and Methods and exposed to 1 μmol/L CD437. Cells were harvested at various times and Western blots were performed as described in the Materials and Methods.
CD437-mediated CPP32 cleavage. HL-60R cells were grown, exposed to 1 μmol/L CD437, and harvested and Western blots were performed as described in the legend to Fig 4.
CD437-mediated CPP32 cleavage. HL-60R cells were grown, exposed to 1 μmol/L CD437, and harvested and Western blots were performed as described in the legend to Fig 4.
A number of antagonists and promoters of apoptosis have recently been described. The bcl-2 family, which now consists of 7 different proteins encoded by 7 different genes, has now been characterized (Vaux and Strasser37 and the references contained within). Bcl-2 and bcl-XL are expressed in numerous cell types and are potent antagonists of apoptosis. We were unable to detect bcl-XL expression in HL-60R or HL-60 cells as has previously been described,43 but found that bcl-2 is highly expressed in these cells and is also cleaved during CD437-mediated apoptosis (Fig 6). Phosphorylation of bcl-2 has been previously described as a mechanism for bcl-2 inactivation during the apoptotic process.44 Whether cleavage of bcl-2 represents another mechanism by which bcl-2 is inactivated remains to be determined. That this cleavage of PARP, CPP32, and bcl-2 does not simply represent random cleavage of a number of proteins is suggested by our inability to detect cleavage of lamin B (data not shown), which is often found cleaved in a variety of forms of programmed cell death.39 41 CD437 also markedly inhibited growth of the K562 cells (Fig 1C) but contrary to HL-60R cells apoptosis was not noted until 144 hours of exposure to CD437, as indicated by internucleosomal degradation demonstrated by gel electrophoresis (Fig 7). We also examined the ability of CD437 to induce PARP cleavage and apoptosis in primary leukemic blasts obtained from a patient with acute myelogenous leukemia. As shown in Fig 8C, enhanced PARP cleavage was noted within 24 hours after exposure to 1 μmol/L CD437, with the apoptotic morphology noted at 48 hours of exposure (Fig 8A and B).
Bcl-2 cleavage during CD437-mediated apoptosis. HL-60R cells were grown in the presence of 1 μmol/L CD437 for various periods of time, the cells were harvested, and Western blots were performed as described in the Materials and Methods.
Bcl-2 cleavage during CD437-mediated apoptosis. HL-60R cells were grown in the presence of 1 μmol/L CD437 for various periods of time, the cells were harvested, and Western blots were performed as described in the Materials and Methods.
DNA fragmentation induced by CD437 in K562 cells. K562 cells were grown as described in the Materials and Methods. CD437 was added to a final concentration of 1 μmol/L, cells were harvested, and DNA was extracted and fractionated by gel electrophoresis as described in the Materials and Methods.
DNA fragmentation induced by CD437 in K562 cells. K562 cells were grown as described in the Materials and Methods. CD437 was added to a final concentration of 1 μmol/L, cells were harvested, and DNA was extracted and fractionated by gel electrophoresis as described in the Materials and Methods.
CD437-mediated apoptosis in primary leukemia cells. Leukemic blasts were isolated as described in the Materials and Methods. Cells were exposed to 1 μmol/L CD437 for various periods of time and PARP cleavage was assessed as previously described. (A) Leukemic cells exposed only to vehicle for 48 hours. (B) Leukemic cells exposed to 1 μmol/L CD437 for 48 hours. (C) CD437-mediated PARP cleavage. Lanes 1 and 3, cells exposed to vehicle only for 24 and 48 hours, respectively. Lanes 2 and 4, cells exposed to 1 μmol/L CD437 for 24 and 48 hours, respectively.
CD437-mediated apoptosis in primary leukemia cells. Leukemic blasts were isolated as described in the Materials and Methods. Cells were exposed to 1 μmol/L CD437 for various periods of time and PARP cleavage was assessed as previously described. (A) Leukemic cells exposed only to vehicle for 48 hours. (B) Leukemic cells exposed to 1 μmol/L CD437 for 48 hours. (C) CD437-mediated PARP cleavage. Lanes 1 and 3, cells exposed to vehicle only for 24 and 48 hours, respectively. Lanes 2 and 4, cells exposed to 1 μmol/L CD437 for 24 and 48 hours, respectively.
CD437 induction of p21WAF1/CIP1 and GADD 45 mRNA expression.Cell cycle progression is regulated through a number of checkpoints. p21, also referred to as p21waf1/cipI and SDI,45-48 forms a quaternary complex with cyclins, cyclin-dependent kinases, and the proliferating cell nuclear antigen,48 resulting in their inhibition and cessation of cell cycle progression.48 The addition of CD437 to breast carcinoma cells results in the rapid increase in p21waf1/cip1 in a p53-independent manner.14 We therefore examined whether CD437 also modulated p21waf1/cip1 in these cells. As shown in Fig 9A, the addition of CD437 resulted in a rapid increase in p21waf1/cip1 mRNA expression. A 10-fold increase in p21waf1/cip1 was noted within 30 minutes of exposure to CD437, with a maximum increase of 80-fold noted at 2 hours (Fig 9B). This elevation in p21waf1/cip1 occurs significantly before the onset of apoptosis. Because HL-60R cells are p53 null,49 CD437 modulates p21waf1/cip1 in a p53-independent fashion. CD437 modulation of p21waf1/cip1 mRNA expression was also examined in K562 cells (Fig 10A). A twofold increase in p21 mRNA expression was noted at 24 hours after the addition of CD437 and significantly before the onset of apoptosis (Fig 10B).
CD437-enhanced p21WAF1/CIP1 mRNA expression in HL-60R cells. Exponentially growing HL-60R cells were exposed to 1 μmol/L CD437 for varying periods of time. Cells were harvested and Northern blots were performed as described in the Materials and Methods. The intensity of each band was scanned using laser densitometry and values were normalized with respect to 18S mRNA signals. (A) A representative Northern blot from two separate determinations. (B) Quantification of a representative experiment.
CD437-enhanced p21WAF1/CIP1 mRNA expression in HL-60R cells. Exponentially growing HL-60R cells were exposed to 1 μmol/L CD437 for varying periods of time. Cells were harvested and Northern blots were performed as described in the Materials and Methods. The intensity of each band was scanned using laser densitometry and values were normalized with respect to 18S mRNA signals. (A) A representative Northern blot from two separate determinations. (B) Quantification of a representative experiment.
CD437-enhanced p21WAF1/CIP1 mRNA expression in K562 cells. Exponentially growing HL-60R cells were exposed to 1 μmol/L CD437 for varying periods of time. Cells were harvested and Northern blots were performed as described in the Materials and Methods. The intensity of each band was scanned using laser densitometry and the values were normalized with respect to 18S mRNA signals. (A) A representative Northern blot from two separate determinations. (B) Quantification of a representative experiment.
CD437-enhanced p21WAF1/CIP1 mRNA expression in K562 cells. Exponentially growing HL-60R cells were exposed to 1 μmol/L CD437 for varying periods of time. Cells were harvested and Northern blots were performed as described in the Materials and Methods. The intensity of each band was scanned using laser densitometry and the values were normalized with respect to 18S mRNA signals. (A) A representative Northern blot from two separate determinations. (B) Quantification of a representative experiment.
The GADD (growth arrest and DNA damage inducible) genes are also noted to be induced by a number of DNA-damaging agents as well as by agents inducting growth arrest (Kersey et al50 and Zhan et al51 and the references contained within). GADD 45 mRNA expression is markedly enhanced after growth arrest (Kersey et al50 and Zhan et al51 and the references contained within). Exposure of HL-60R cells to CD437 also resulted in a rapid (within 1 hour) increase in GADD 45 mRNA expression (Fig 11A and B) before the onset of apoptosis. CD437 modulation of GADD 45 mRNA expression was not noted in K562 cells (data not shown).
CD437-enhanced GADD 45 mRNA expression. Exponentially growing HL-60R cells were exposed to 1 μmol/L CD437 for varying periods of time. Cells were harvested and Northern blots were performed as described in the Materials and Methods. The intensity of each band was scanned using a laser densitometer and values were normalized with respect to 18S mRNA signals. (A) A representative Northern blot assay from two separate determinations. (B) Quantification of a representative experiment.
CD437-enhanced GADD 45 mRNA expression. Exponentially growing HL-60R cells were exposed to 1 μmol/L CD437 for varying periods of time. Cells were harvested and Northern blots were performed as described in the Materials and Methods. The intensity of each band was scanned using a laser densitometer and values were normalized with respect to 18S mRNA signals. (A) A representative Northern blot assay from two separate determinations. (B) Quantification of a representative experiment.
DISCUSSION
The differentiation of the HL-60 leukemia cell line and acute promyelocytic leukemia cell lines exposed to RA in vitro has been documented by a number of investigators (Chomienne et al52 and the references contained within). The recent observation that the vast majority of patients with acute promyelocytic leukemia achieve a complete remission upon treatment with RA has generated a great deal of enthusiasm and interest in the use of retinoids as a treatment for this disease.53-55 This interest has been further accentuated by the two observations that the RA-mediated remission is not associated with aplasia but a continual differentiation of the leukemic cells into mature granulocytes and that the leukemic blasts possess a unique PML-RARα gene fusion as a result of a 15-17 translocation.55,56 Numerous mechanisms have been proposed by which PML-RARα expression interferes with normal myeloid differentiation and by which ligand binding to the PML-RARα fusion product results in the progression of normal differentiation.57-59 Unfortunately, the other subtypes of acute myelogenous leukemia (AML) are refractory to RA-mediated differentiation both in vivo as well as in vitro.60 In addition, the RA-induced remission in patients with acute promyelocytic leukemia is only transient, with a mean duration of approximately 6 months.61 The observation that CD437 is able to induce apoptosis in a number of RA-sensitive and -resistant leukemia cell lines would suggest that CD437 may be used therapeutically in the treatment of this disease.
CD437 induces apoptosis and not differentiation in the leukemic cells, as evidenced by the lack of acquisition by the cells of those phenotypic makers associated with myeloid maturation (data not shown). That CD437 rapidly induced apoptosis in these cells was indicated by multiple parameters. Incubation of the cells with CD437 resulted in the rapid cleavage of CPP32 and PARP, the onset of morphologic changes indicative of apoptosis, and internucleosomal degradation of the DNA. These markers of apoptosis are rapidly induced in these cells by CD437 with CPP32 and PARP cleavage noted within 2 hours. In addition, the time course associated with CD437-mediated apoptosis in these cells is significantly different from RA-mediated differentiation of HL-60 cells, in which no evidence of apoptosis is noted within the first 24 hours of exposure to RA.62 The mechanism by which CD437 induces apoptosis in the leukemic cells is unclear. A large number of intermediaries have been implicated in the signalling of the apoptotic process. These intermediaries have included tyrosine kinases, steroid receptors, ceramides, inositol phosphates, and a variety of cytokine receptors (Vaux and Strasser37 and the references contained within). Perhaps the best described have been the ceramide and FAS pathways. Whether any of these pathways are involved in CD437-mediated apoptosis remains to be defined. However, it is clear that signalling through the retinoid nuclear receptor pathways does not appear to be involved because, as indicated previously, HL-60R cells do not express RARβ or RARγ, as indicated by RNase protection assay, and express a truncated RARα receptor. The HL-60R truncated RARα possesses a 14-fold higher kd in terms of RA binding and 70% reduction in receptor number, rendering it inactive to RA-mediated antiproliferation and differentiation.16,17,63 CD437 possesses a 300-fold increase in kd in terms of binding to the wild-type RARα and a 70-fold increase in the required concentration for 50% maximal transactivation of the wild-type RARα nuclear receptor when compared with RA.15 Thus, it appears very unlikely that CD437 would bind and transactivate the truncated RARα receptor found in HL-60R cells that cannot be activated by RA.
CD437 rapidly induces p21waf1/cip1 expression in HL-60R cells. Increased p21waf1/cip1 expression is noted within 30 minutes, significantly before the onset of apoptosis. We have previously shown that CD437 rapidly induces p21waf1/cip1 expression in breast carcinoma cells through a p53-independent process.14 In addition, p21waf1/cip1 expression occurs through the unique method of stabilization of message.64 Akaski et al65 have previously documented a similar mechanism in irradiation-induced p21waf1/cip1 message in KG-1 leukemic cells. We have previously shown that the CD437 increased expression of p21waf1/cip1 in breast carcinoma cells is responsible for the observed G1 cell cycle arrest that occurs significantly before apoptosis.14 We have found that fibroblasts lacking p21waf1/cip1 will not undergo G1 arrest upon exposure to CD437, whereas fibroblast possessing p21waf1/cip1 readily undergo G1 cell cycle arrest; both cell types undergo apoptosis (unpublished data). Whether the CD437-mediated increase in p21waf1/cip1 results in G1 arrest in HL-60R cells is presently being determined. Numerous studies have examined the role of p21waf1/cip1 in the apoptotic process.62,66-68 The majority of studies have suggested that p21waf1/cip1 plays no role in p53-mediated apoptosis.62,66,68 Deng et al66 have found that thymocytes lacking p21waf1/cip1 still undergo apoptosis after irradiation. However, controversy still exists regarding the role of p21waf1/cip1 in apoptosis since Sheikh et al67 found that high expression of p21waf1/cip1 in breast cancer cells results in apoptosis. We also noted a rapid increase in GADD45 mRNA expression HL-60R cells after incubation with CD437. GADD45 mRNA expression is enhanced by a large variety of stimuli, including hypoxia, X irradiation, and genotoxic drugs (Kearsey et al69 and the references contained within). Modulation of GADD45 massage can occur through both p53-dependent and -independent pathways as well as stabilization of message (Kearsey et al69 and the references contained within). The function of GADD45 remains unclear. Overexpression of GADD45 has resulted in growth arrest in some cells and apoptosis in others (Kearsey et al69 and Zhan et al70 and the references contained within). Whether the CD437-mediated increased expression of GADD45 plays a role in CD437-mediated apoptosis remains to be defined.
Chemotherapy has been highly effective in inducing remission in acute myelogenous leukemia.71 Unfortunately, despite intensive chemotherapy, the vast majority of patients still relapse and succumb to their disease.71 Therefore, new drugs with different mechanisms of actions need to be developed that can be used alone or in conjunction with chemotherapy to treat this disease. RA has certainly proven to be a powerful tool in the treatment of acute promyelocytic leukemia.52-54 Whether CD437 will similarly prove to be therapeutically useful in the treatment of other forms of leukemia remains to be determined.
Supported in part by the Medical Research Services of the Department of Veterans Affairs (J.A.F.) and National Institutes of Health Grants No. CA63335 (J.A.F.) and CA51993 (M.I.D.).
Address reprint requests to Joseph A. Fontana, MD, PhD, 655 W Baltimore St, Bressler Research Bldg, Room 9-031, Baltimore, MD 21201.